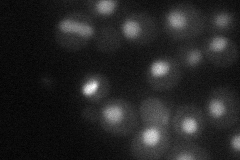
YBR270C
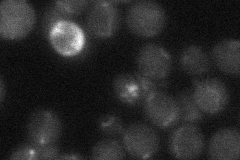
YBR270C

View description
Subunit of TORC2, a membrane-associated complex that regulates actin cytoskeletal dynamics during polarized growth and cell wall integrity; interacts with Slm1p and Slm2p, homologous PH domain-containing TORC2 substrates; similar to Bit61p
Localization:
Intensity:
Fold change:
Significance:
-
C’ GFP library in SD

below threshold16.89 -
N' NOP1pr-GFP in SD

cytosol,nucleus49.5652 -
N' TEF2pr-mCherry in SD
cytosol33.6148 -
N' NATIVEpr-GFP in SD
below threshold21.3299 -
N' TEF2pr-VC and Cyto-VN in SD

#N/A0 -
C’ GFP library in SD+DTT

cytosol18.041.06No -
C’ GFP library in SD+H2O2

cytosol17.861.05No -
C’ GFP library in Starvation Media

cytosol17.491.03No -
C’ GFP library on the background of Pup2-DaMP

below threshold -
C’ GFP library on the background of CCT mutant

below threshold18.03371.06718No
